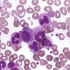

A 54-year-old female presents with symptoms of fatigue, unexplained weight loss, enlarged spleen and night sweats. Peripheral blood shows a markedly increased WBC. Examine the blood smear. Click here to see the blood smear as a whole slide image.
Your diagnosis is: